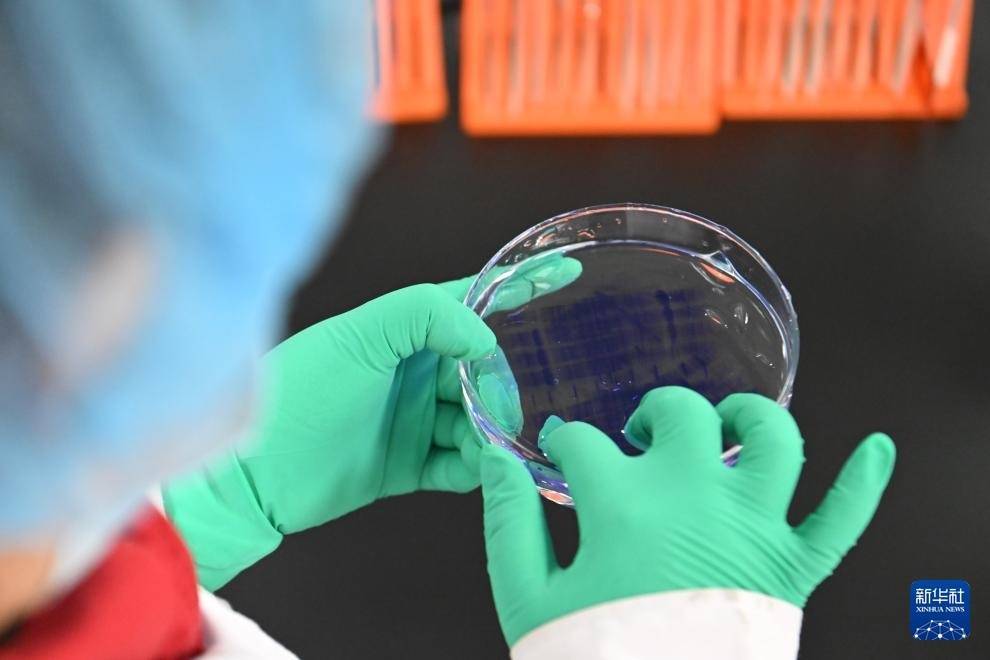

在“十四五”圆满收官在即、“十五五”即将开启的重要历史节点配资平台官网,中央经济工作会议在京举行。会议将“坚持创新驱动,加紧培育壮大新动能”列为明年经济工作重点任务之一。
r国家统计局新闻发言人付凌晖表示,新能源、新材料、航空航天、低空经济等发展潜力巨大,量子科技、生物制造、具身智能等前景广阔,未来有望成为新兴支柱产业,将有力支撑新动能发展壮大。
r
2025年12月4日,在南京人工智能生态街区的“AI·模坊”南京智能体集散中心,一款机器人在打招呼。新华社记者 季春鹏 摄
r
2025年2月20日,在位于京津中关村科技城的中科拜克(天津)生物药业有限公司,实验人员在检验生物制品蛋白分子量。新华社记者 孙凡越 摄
r以场景为抓手
r从写字楼下的无人机外卖到跨海运输的直升机,从应急救援到景区观光,低空应用场景正加速拓展。
r
无人机在安徽合肥骆岗公园配送外卖(2024年7月5日摄,无人机照片)。
r11月17日,零重力飞机工业(合肥)有限公司与景秀旅游签署战略合作协议并落地50架ZG-ONE鹊飞机型采购订单。
r
图为电动垂直起降飞行器(eVTOL)零重力ZG-ONE鹊飞。受访者供图
r“零动力飞机工业自成立以来,始终以科技自立自强为根本导向。”零重力飞机工业(合肥)有限公司联合创始人石红介绍说,“目前推出的4款机型正逐步实现从核心技术到关键零部件的全面自主可控,以期更好地服务当下到未来的多元化低空应用场景。”
r
图为电动固定翼飞机(eCTOL)零重力RX1E-S。受访者供图
r7月22日,峰飞航空科技向合利创兴智能交付全球首架获颁“适航三证”(TC、PC和AC)的吨级以上eVTOL(电动垂直起降)航空器。
r
这是在交付仪式现场展示的V2000CG凯瑞鸥电动垂直起降航空器(2025年7月22日摄)。新华社记者 方喆 摄
r合利创兴智能总裁胡斌表示,他们这一次的合作已经和峰飞公司达成了三台航空器业务的合作。“未来,我们应用的场景包括山体物流的运输,跨海运输,岛与岛之间的运输。”胡斌说。
r
这是V2000CG凯瑞鸥电动垂直起降航空器交付仪式现场(2025年7月22日摄)。新华社记者 方喆 摄
r今年以来,不少低空飞行器制造企业都收获了上百架的飞行器订单。订单旺盛反映了市场需求高涨,彰显了业界对低空经济发展前景的坚定信心。根据中国民航局预测,2025年,我国低空经济的市场规模将达到1.5万亿元,到2035年更有望达到3.5万亿元。
r
2025年11月21日,观众在长沙国际会展中心参观展览。当日,2025湖南(国际)通用航空及低空经济产业博览会开幕。新华社记者 陈振海 摄
r工业和信息化部总工程师谢少锋表示,下一步,组织实施国家科技重大专项和国家重点研发计划,开展专项行动,培育新产业、打造新动能,加快发展生物制造、低空产业。
r
2025年11月22日,一架电动垂直起降飞行器停在全新亮相的零碳水上机场(无人机照片)。新华社记者 方喆 摄
r以转型为驱动
r在山西转型综合改革示范区,山西烁科晶体有限公司的生产车间内,碳化硅晶锭正悄然“成长”,化身为薄如蝉翼的碳化硅晶片,成为卫星通信、5G网络、新能源汽车等战略性新兴产业不可或缺的核心器件。
r公司总经理助理毛开礼告诉记者,只有把核心技术牢牢掌握在自己手中,才能保障产业链、供应链安全,这也是践行“科技报国”的最直接体现。
r
图为山西烁科晶体有限公司厂区。受访者供图
r碳化硅单晶制备曾长期被国外技术垄断。烁科晶体历经多年技术攻关,基本实现生产设备国产化,已成为国内碳化硅单晶衬底研发生产的领军企业,年产能力提升至30万片。
r“新兴的AR光学赛道方面,我们正在全力提升12英寸产品质量与产能,旨在占据未来产业变革的先机。”毛开礼介绍说。
r
这是山西烁科晶体有限公司生产车间。受访者供图
r山西是煤炭大省,近年来,山西转型综改示范区系统布局多元转型路径,积极培育新兴产业,推动“新枝结硕果”,重点培育出第三代半导体、新材料、合成生物等八大产业链,推动形成了一批具有全国影响力的新兴产业集群。
r
图为山西石器时代新材料科技有限公司生产的特种纳米碳酸钙。新华社记者 柴婷 摄
r而因“二汽”而闻名的湖北十堰,是我国重要的汽车生产基地。近年来,随着新能源等新兴产业快速崛起,这座过去以传统商用车为主的汽车城,抢抓转型机遇,不断延伸拓展产业链条。上千家各类汽车企业集聚十堰,能生产零部件4000余种,产品辐射全国并出口到72个国家和地区。
r十堰市张湾区科学技术和经济信息化局副局长黄铄清在采访中表示,今年以来,他们立足区域发展实际,聚焦高端化、智能化发展方向,打造以汽车产业为主导的新能源新材料等12个产业集群和8大特色园区,全面提升产业能级和核心竞争力,加快推进千亿级示范区建设,为区域高质量发展注入强劲动能。
r
以应用为突破
r12月5日,四川成都。全国首个具身智能机器人生态平台核心载体——“机器人大世界”一期(具身智能机器人大卖场)正式开门迎客,成为公众触摸“未来生活”的一扇窗。
r
2025年,“具身智能”首次写入政府工作报告。具身智能机器人加速迭代,逐步从生产车间步入生活场景。
r北京人形机器人创新中心首席运营官李春枝表示,产业界对“天工”的拟人奔跑的认可度比较高,下一步,会把更多的精力投入到开源开放,做好行业赋能。
r
2025年6月17日,在北京人形机器人创新中心有限公司,人形机器人“天工2.0”向参观者致意。新华社记者 郑焕松 摄
r记者从日前举行的“2026中国信通院深度观察报告会”上获悉,具身智能作为大模型与机器人结合的产物,在政策与资本的推动下快速发展,融资金额超400亿元,产业上下游企业达350多家。
r
2025年9月12日,媒体采访团在上海擎朗智能科技有限公司观看人形机器人表演。新华社记者 王翔 摄
r国家发展改革委政策研究室副主任、新闻发言人李超表示,近年来,在创新引领和需求释放的双重作用下,以人形机器人为代表的具身智能产业规模,正在以超50%的增速跨越式发展。根据市场调研机构预测,2030年将达到千亿元市场规模。
r
2025年12月4日,在湖北人形机器人创新中心,数据采集员操作人形机器人进行咖啡店场景的数据采集。新华社记者 肖艺九 摄
r“十四五”时期,我国科技创新成果丰硕,国家综合创新能力排名由第14位提升至第10位。科技创新和产业创新加速融合,规上高技术制造业增加值较“十三五”末增长42%。迈上“十五五”新征程,我国发展环境面临深刻复杂变化,科技创新被赋予更重要的使命。
r
2025年6月16日,机器人在位于北京经济技术开发区的小米汽车工厂车间流水线上作业。新华社记者 郑焕松 摄
r科技部部长阴和俊表示,面向“十五五”,将锚定科技强国建设目标,以“十年磨一剑”的坚定决心和顽强意志,加快实现高水平科技自立自强,为推进中国式现代化作出更大贡献。
r
这是深圳河套深港科技创新合作区(2025年4月24日摄,无人机照片)。新华社记者 梁旭 摄
r统筹:吴炜玲
r编导:何莉
r记者:白斌、邓浩然、刘扬涛、潘志伟
r配音:王帅龙
r新华社音视频部制作
r(新华网)配资平台官网
先锋配资提示:文章来自网络,不代表本站观点。